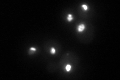

View description
RNA polymerase I subunit A43
Localization:
Intensity:
Fold change:
Significance:
-
C’ GFP library in SD
nucleolus81.79 -
N' NOP1pr-GFP in SD

nucleus,nucleolus145.265 -
N' TEF2pr-mCherry in SD

nucleus,nucleolus60.4029 -
N' NATIVEpr-GFP in SD

nucleolus82.9319 -
N' TEF2pr-VC and Cyto-VN in SD

nucleus,nucleolus39.7521 -
C’ GFP library in SD+DTT

nucleolus48.50.59Yes -
C’ GFP library in SD+H2O2

nucleolus89.631.09No -
C’ GFP library in Starvation Media

nucleolus30.710.37Yes -
C’ GFP library on the background of Pup2-DaMP

nucleolus -
C’ GFP library on the background of CCT mutant

nucleolus92.64371.13266No
